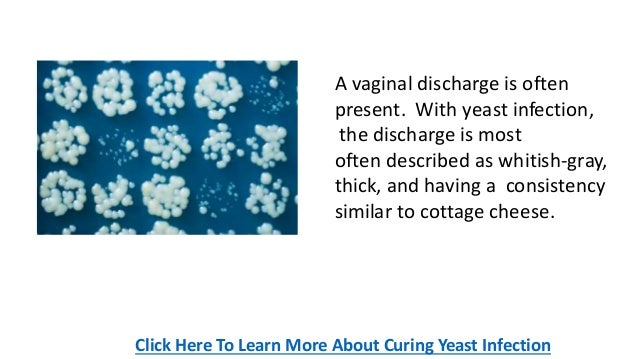

Cottage Cheese Discharge During Intercourse | Pleasant for you to my website, in this occasion I am going to provide you with with regards to Cottage Cheese Discharge During Intercourse. And now, this is the 1st graphic:

ads/wallp.txt
Why not consider graphic over? can be that wonderful???. if you feel consequently, I'l m provide you with a number of graphic once more below:


Through the thousand photos on-line with regards to Cottage Cheese Discharge During Intercourse, picks the top libraries along with best image resolution exclusively for you, and now this photos is actually considered one of images libraries inside our best images gallery with regards to Cottage Cheese Discharge During Intercourse. Lets hope you may enjoy it.


ads/wallp.txt

ads/bwh.txt
keywords:
Canesten Vaginal Cream for Treatment of Vaginal Fungal ...
Monistat’s Quest to End Unfair Stigma on Yeast Infections ...
Women's Health by Sashel
Smelly Vaginal Discharge | New Health Guide
Crinone Gel Yeast Infection Guide
Cottage Cheese Discharge: Causes and Treatments | New ...
The Truth about Vaginal Discharge during Pregnancy ...
Signs Of Yeast Infection
Vaginal Thrush
How Much Probiotic For Yeast Infection And Which ...
Food related medical terms: Cottage cheese appearance
PPT - Infection of the genital tract PowerPoint ...
Vaginal Discharge during Pregnancy: What is Safe and What ...
Be yeast infection feww forever by rush young - Issuu
13 Things You Might Not Know About Yeast Infections ...
Clear Mucus Discharge With Blood Streaks Before Period
White discharge | causes, symptoms, prevention
The Truth about Vaginal Discharge during Pregnancy ...
Vaginal Discharge..How to Diagnose
Sti ppt-editable
5 Causes of Vaginal Discharge: Types, Symptoms, Remedies ...
Is canex t cream for virginal discharge Buy Products In ...
Vaginal Yeast Infection - Causes, Symptoms Treatment ...
Yeast Infection
Lecture fourth years genital infection web site
Clumps discharge from vagina - Women's Health - MedHelp
H:\\Infections In Pregnancy 2008 Cert Day 1[1]
Yeast Infection Renewable Discharge, Stay Ahead With Our ...
8 Secrets About Vaginal Discharges That No One Wants To ...
Clear watery discharge-Is it normal or is it a disease?
Decode Your Discharge | The Doctors TV Show
These Are The Things That Vagin@l Discharge Might Tell You ...
How to Treat Candida Naturally? - Your Health Tube
Vaginal discharge color - Women Health Info Blog
White chunky discharge: brown, yellow, green, pink, bloody
other post:
0 Response to "Ideas 50 of Cottage Cheese Discharge During Intercourse"
Post a Comment